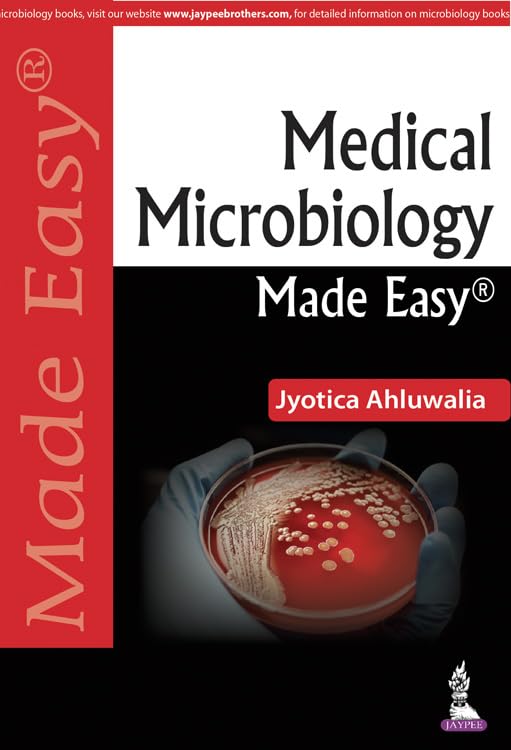
MEDICAL MICROBIOLOGY MADE EASY

MEDICAL MICROBIOLOGY MADE EASY
MEDICAL MICROBIOLOGY MADE EASY is backordered and will ship as soon as it is back in stock.
Couldn't load pickup availability
Genuine Products Guarantee
Genuine Products Guarantee
We guarantee 100% genuine products, and if proven otherwise, we will compensate you with 10 times the product's cost.
Delivery and Shipping
Delivery and Shipping
Products are generally ready for dispatch within 1 day and typically reach you in 3 to 5 days.
Book Details
-
Publisher: Jaypee Brothers Medical Publishers
-
Language: English
-
Edition: First Edition (1 January 2018)
-
Pages: 436
-
Binding: Paperback
-
ISBN: 9789352700974
-
Weight: 372 g
About the Book
This First Edition publication from Jaypee Brothers Medical Publishers delivers a comprehensive and well-structured academic resource ideal for medical students and healthcare learners. With 436 pages of updated explanations, organized chapters, and clear conceptual coverage, the book supports effective exam preparation, classroom study, and self-learning. Its lightweight paperback format ensures ease of handling while maintaining high-quality printing and layout for an enhanced learning experience.